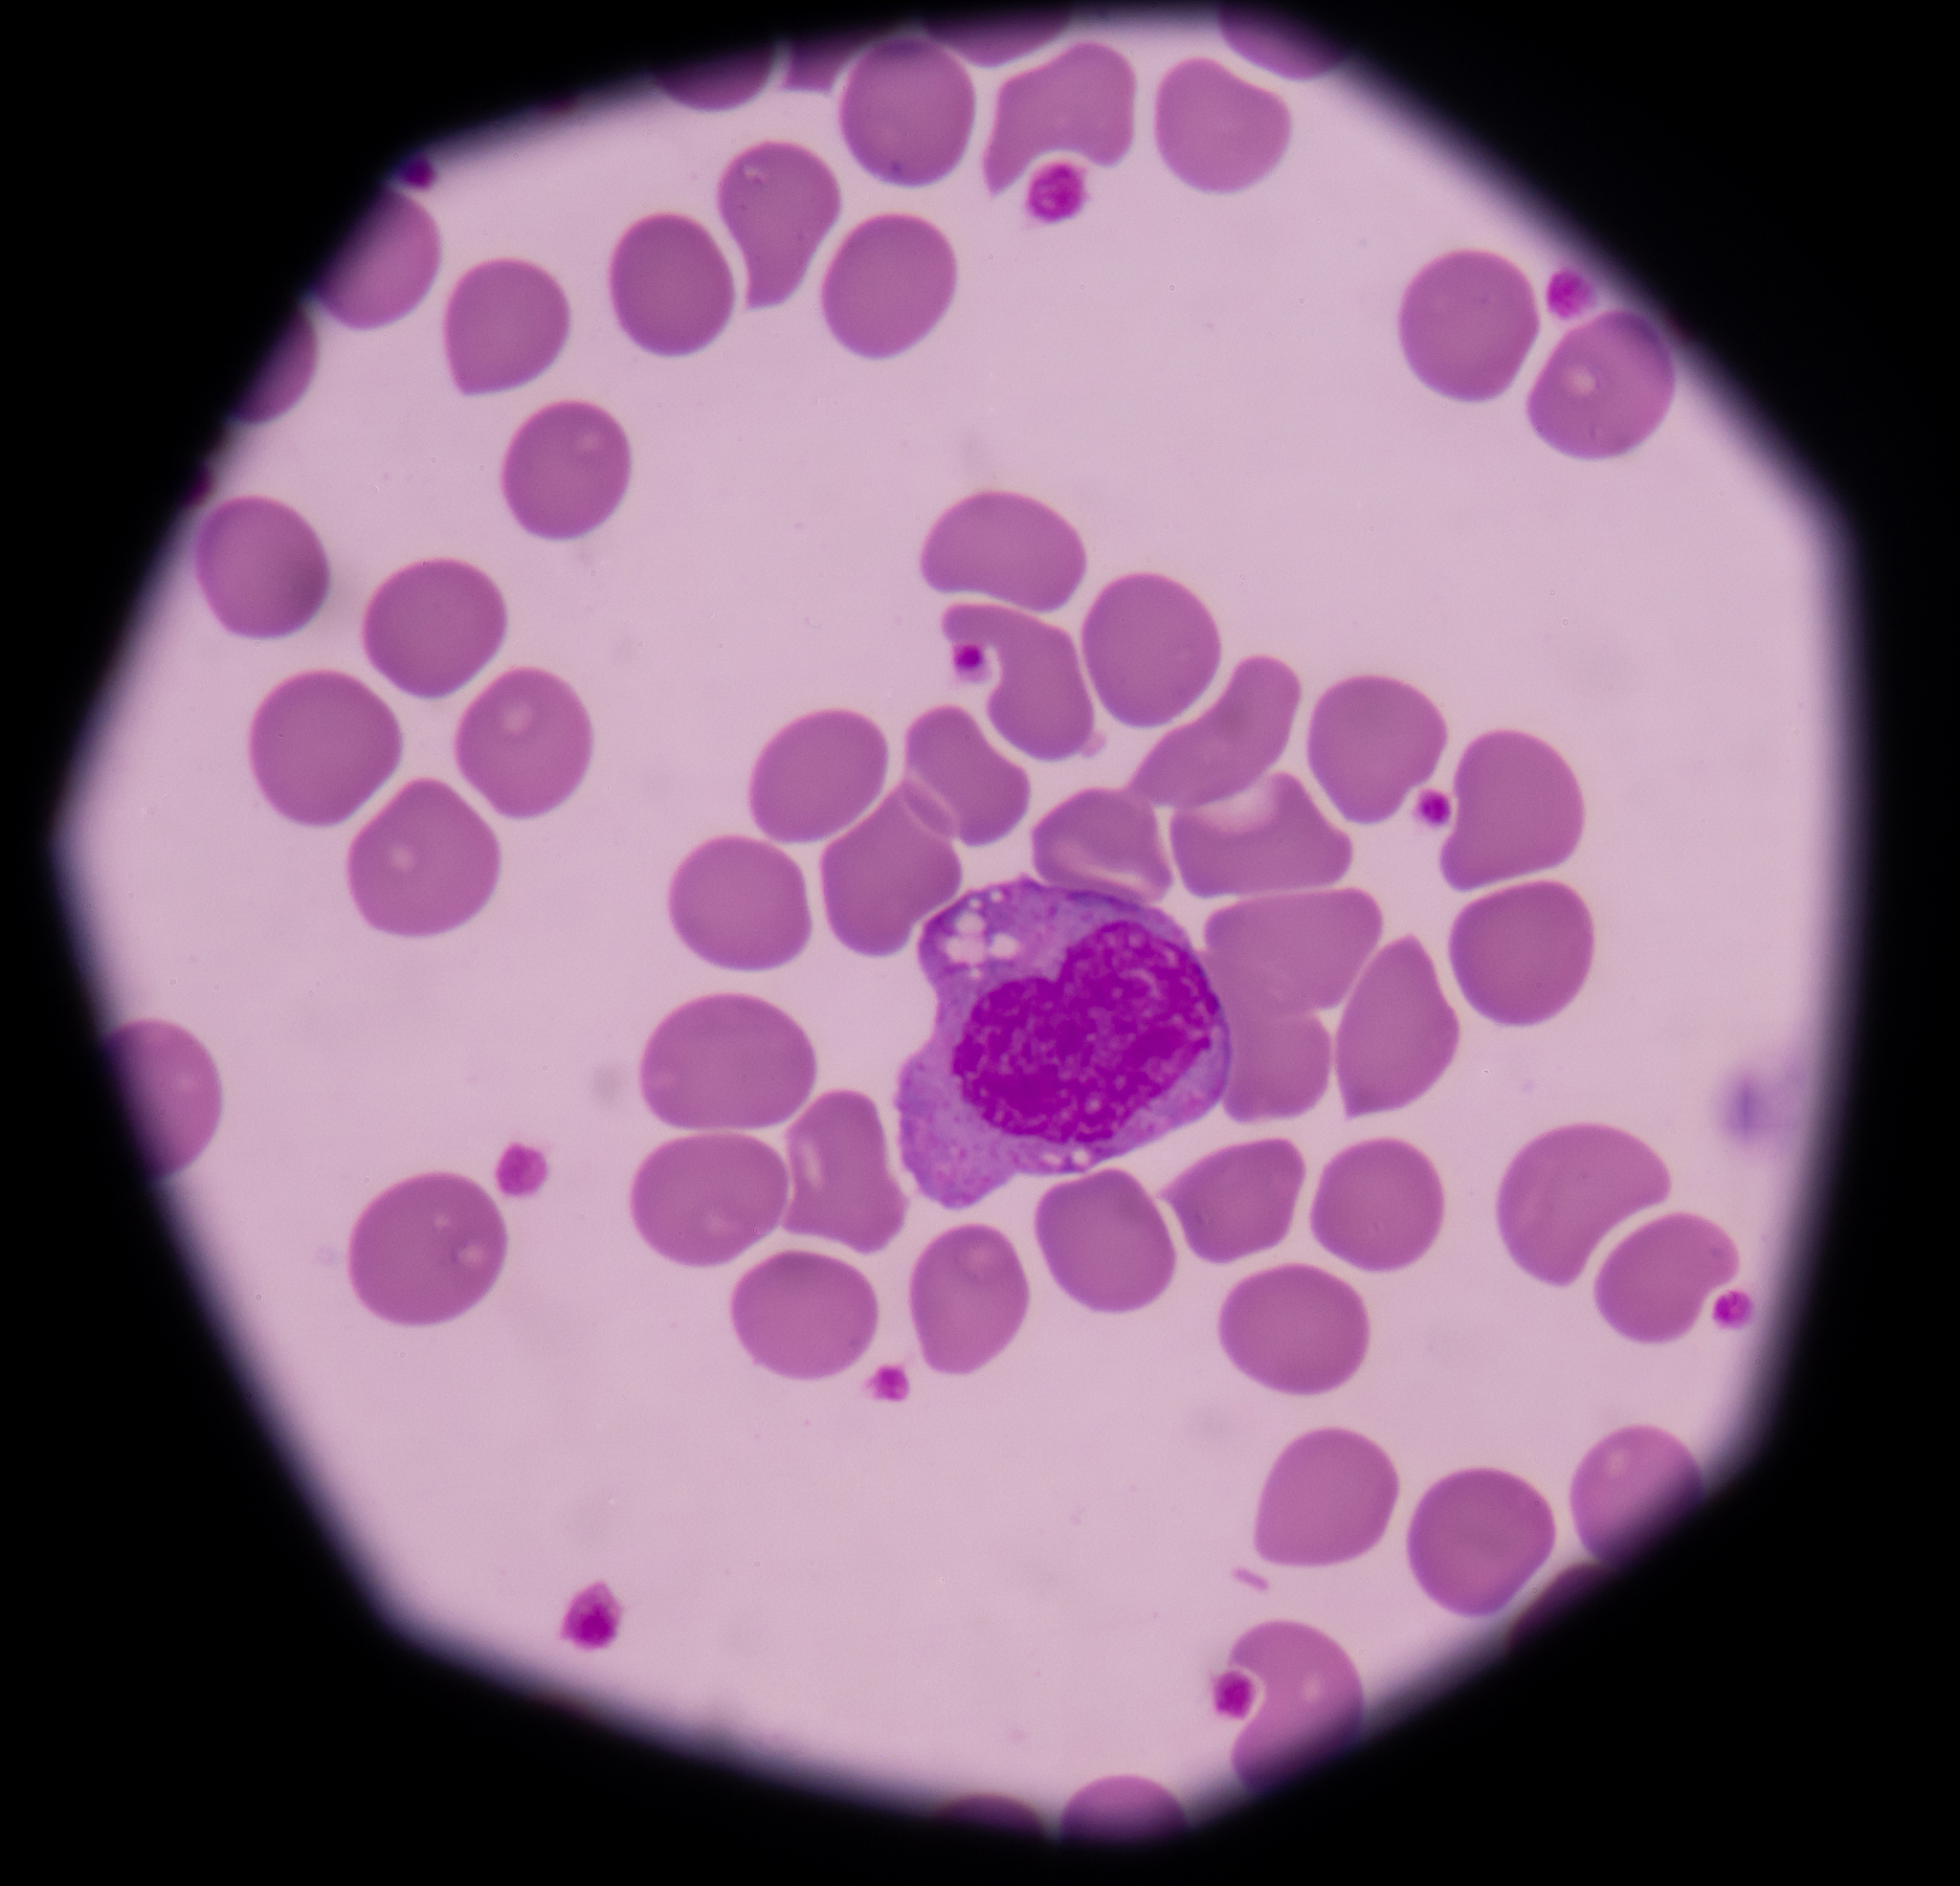
白细胞分类及正常比例范围

白细胞分类及正常比例范围
白细胞分类及正常比例范围
白细胞是人体免疫系统的重要组成部分,负责抵抗感染和疾病。它们在血液中循环,并在需要时迁移到组织中发挥作用。白细胞可以分为不同的类型,每种类型都有其特定的功能。
白细胞种类
人体内的白细胞主要分为以下五种类型:
- 中性粒细胞: 吞噬和杀灭细菌。2. 淋巴细胞: 识别和消灭病毒、细菌和其他病原体,并产生抗体。3. 单核细胞: 吞噬和消化细胞碎片、细菌和其他异物,并参与免疫反应。4. 嗜酸性粒细胞: 参与过敏反应和对抗寄生虫感染。5. 嗜碱性粒细胞: 释放组胺和其他参与炎症反应的物质。
正常白细胞比例
假设总共有100个白细胞,那么正常情况下各种白细胞的比例大致如下:
- 中性粒细胞: 55-70个* 淋巴细胞: 20-35个* 单核细胞: 3-8个* 嗜酸性粒细胞: 1-3个* 嗜碱性粒细胞: 0-1个
需要注意的是,这只是一个大致的参考范围。个体之间,甚至同一个人在不同时间,白细胞的比例都可能会有所不同。
影响白细胞比例的因素
一些因素可能会影响白细胞的比例,例如:
- 年龄: 新生儿和婴儿的淋巴细胞比例通常较高。* 健康状况: 感染、炎症、自身免疫性疾病和其他疾病都可能导致白细胞比例的变化。* 药物: 某些药物,例如皮质类固醇,可能会影响白细胞的产生和分布。
如果您有任何关于白细胞计数或比例的疑问,请咨询医生或其他医疗保健专业人员。他们可以根据您的具体情况解释您的检查结果。
原文地址: https://www.cveoy.top/t/topic/b6pY 著作权归作者所有。请勿转载和采集!